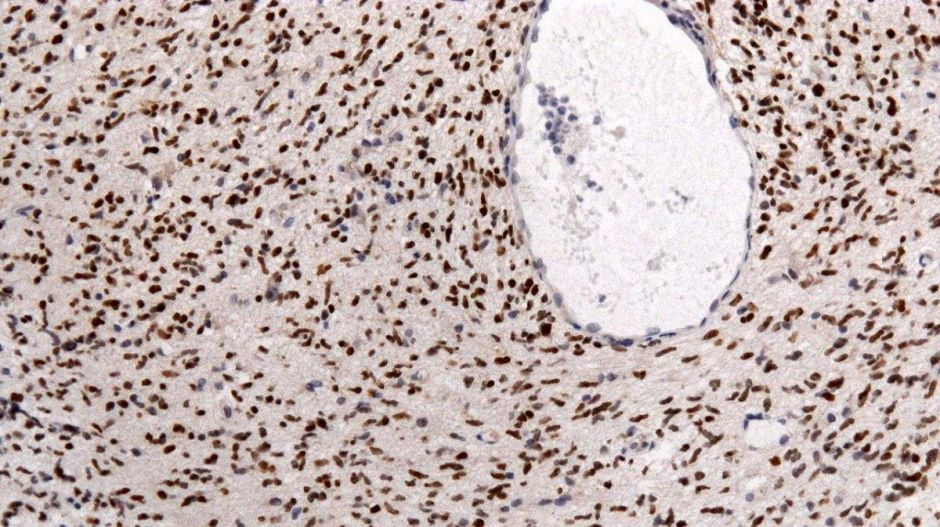
Rózsaszínen fénylő rákos sejtek könnyíthetik meg a sebészek dolgát

Rózsaszínen fénylő rákos sejtek könnyíthetik meg a sebészek dolgát
Elég a betegeknek egy speciális folyadékot meginni ahhoz, hogy műtét alatt világítsanak a rákos sejtek az agyban.
Olyan vegyület segítheti a rák elleni küzdelmet, amelynek hatására az agytumor rózsaszínen világít UV-fény alatt – írja a BBC. Ez ugyanis megkönnyítheti a sebészek számára a rákos sejtek megkülönböztetését az egészséges agyszövettől.
Egy vizsgálat során 99 előrehaladott agydaganatban szenvedő emberrel itattak olyan folyadékot műtét előtt, amely tartalmazta az 5-ALA elnevezésű vegyületet,
Közülök 85 ember esetén láttak fluoreszkáló rákos sejteket a sebészek a műtét során.
A kutatások egyik következő lépése az lehet, hogy a technikát agydaganatban szenvedő gyerekeken is tesztelik.
FOTÓ: Wikipédia

Tetszett a cikk?

Az Azonnali hírlevele
Nem linkgyűjtemény. Olvasmány. A Reggeli fekete hétfőn, szerdán és pénteken jön, még reggel hét előtt – tíz baristából kilenc ezt ajánlja a kávéhoz!
Feliratkozásoddal elfogadod az adatkezelési szabályzatot.

